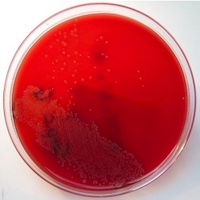

Search
Search Results
##search.searchResults.foundPlural##
-
Use of XpertMTB/RIF for Mycobacterium tuberculosis identification
2010Downloads: 691HTML: 179 -
-
Assessment of potential factors that support the endemicity of cholera in Nigeria from food handlers, health workers and the environment Potential factors that support the endemicity of cholera in Nigeria
910Downloads: 517HTML: 41 -
Microbial diagnosis of periodontal pathogens
1203Downloads: 1088 -
Microbial biofilm: a “sticky” problem
1547Downloads: 730HTML: 236 -
-
A case of dirofilaria in human eye localization
1806Downloads: 1873 -
Reporting epidemiology of antibiotic resistance
3628Downloads: 1652HTML: 402 -
Aeromonas spp.: an emerging pathogen?
2748Downloads: 896HTML: 449 -
A rare case report of post-Covid Mucormycosis-Aspergillosis co-infection
602Downloads: 350HTML: 16 -
-
-
Microbiological evaluation of open and sealed tattoo inks
2925Downloads: 1029HTML: 373 -
Klebsiella pneumoniae KPC: first isolations in Italy
1785Downloads: 1141 -